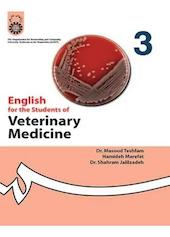
انگلیسی برای دانشجو�یان رشته دامپزشکی

راهنمای واژگان و نکات کاربردی Evolve جلد 1
لسلی آن هندرا
4.3
(7)

راهنمای واژگان و نکات کاربردی Evolve جلد 3
لسلی آن هندرا
5
(6)

راهنمای واژگان و نکات کاربردی Evolve جلد 2
لسلی آن هندرا
3
(5)

راهنمای واژگان و نکات کاربردی Evolve جلد 4
لسلی آن هندرا
4
(5)

504 واژگان خیلی ضروری در زبان انگلیسی
مورای برامبرگ
3.8
(6)

انگلیسی برای دانشجویان رشته زیست شناسی سلولی و مولکولی
سعید آیریان
منتظر امتیاز

صفر تا صد از گرامر تا مکالمه
بابک قلاوند
3
(2)

انگلیسی برای دانشجویان رشته علوم و صنایع غذایی
ابراهیم جدیری سلیمی
5
(1)

انگلیسی برای دانشجویان رشته مدیریت صنعتی
مسعود کسائی
منتظر امتیاز

Amerrycountry
زادمهر ترابی
5
(1)
انگلیسی برای دانشجویان رشته دامپزشکی
مسعود تشفام
منتظر امتیاز

آموزش صرف عربی
عبدالهادی فقهیزاده
منتظر امتیاز
نوع محتوا
فقط فیدیپلاس
فقط راوی
فقط کتابهای موجود
نویسنده، مترجم یا راوی
ناشر
